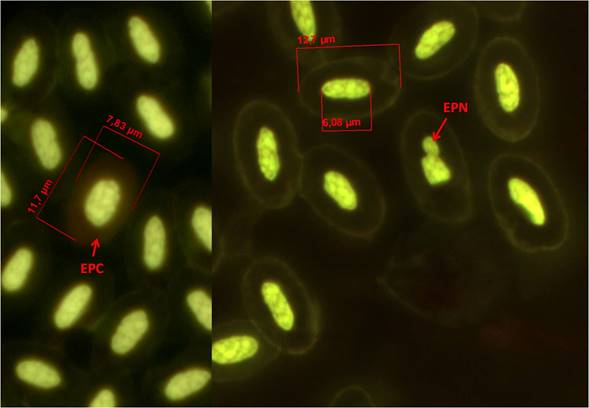
Sangre de Chen caerulescens, Eritrocito policrom&aacute;tico (EPC), Eritrocito con prolongaci&oacute;n nuclear (EPN), Tinci&oacute;n: anaranjado de acridina (100x).
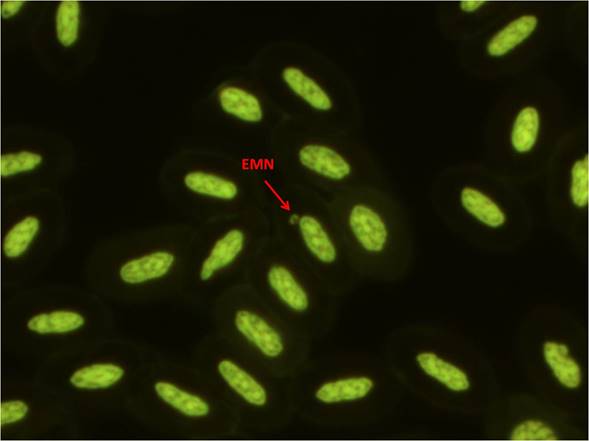
Sangre de Chen caerulescens, Eritrocito micronucleado (EMN), Tinci&oacute;n: anaranjado de acridina (100x).
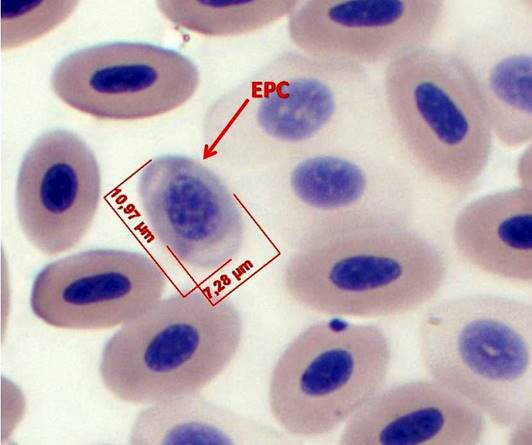
3. Sangre de Chen caerulescens, Eritrocito policrom&aacute;tico (EPC), Tinci&oacute;n Wrigth-Giemsa (100x).

Artículo original
Relación heterófilo/linfocito, frecuencia espontánea de eritrocitos micronucleados y prolongaciones nucleares en el ganso nevado (Chen caerulescens): Una propuesta como posible biomonitor de estrés y genotóxicos ambientales
Heterophil to lymphocyte ratio, basal frequency of micronucleated erythrocytes and nuclear extensions in the snow goose (Chen caerulescens): A proposal as possible stress and environmental genotoxicity biomonitor
Relación heterófilo/linfocito, frecuencia espontánea de eritrocitos micronucleados y prolongaciones nucleares en el ganso nevado (Chen caerulescens): Una propuesta como posible biomonitor de estrés y genotóxicos ambientales
Huitzil, vol. 18, núm. 1, 2017
Sociedad para el Estudio y Conservación de las Aves en México, A.C. (CIPAMEX)
Recepción: 28 Enero 2016
Aprobación: 07 Noviembre 2016
Resumen: Existen organismos silvestres que son altamente vulnerables ante estresores antropogénicos y naturales, estos organismos pueden ser de utilidad para evaluar la salud ambiental mediante diferentes indicadores confiables, sencillos, rápidos, económicos para determinar y si es posible reducir estos efectos negativos. En este estudio proponemos al ganso nevado (Chen caerulescens) como posible biomonitor de estrés y genotóxicos ambientales mediante la relación heterófilo/linfocito (h/l), la prueba de micronúcleos (EMN), prolongaciones nucleares en eritrocitos (EPN) y eritrocitos policromáticos (EPC). Durante la temporada de caza (2012-2013) en el humedal de Málaga, Durango, México, colectamos 18 organismos. Los eritrocitos fueron las células más abundantes, de núcleo y morfología elípticos, de tamaño 12.68 ± 0.89 µm. Observamos heterófilos (11.07±1.32 µm), eosinófilos (9.67±1.26 µm), basófilos (5.75 ± 0.78 µm), monocitos (10.49±1.36 µm) y linfocitos (6.53±1.0 µm). No identificamos alteración en las proporciones ni en la morfología de leucocitos, sin embargo, es necesario un mayor número de organismos para establecer los parámetros sanguíneos de base normal para esta especie. La relación h/l fue de 0.41 ± 0.11 este valor es similar a lo reportado para esta y otras especies de aves consideradas como sanas. Establecimos la frecuencia basal de EMN (2.6±1.45), EPN (249.2 ± 89.74) y EPC (156.5 ± 50). El ganso nevado es un organismo que se perfila como buen candidato a biomonitor ambiental debido a la frecuencia basal de su relación h/l, EMN, EPN y EPC, pero debe probarse en condiciones estandarizadas y a través de estudios en zonas con y sin contaminación.
Palabras clave: Biomonitor, Chen caerulescens, eritrocitos micronucleados, eritrocitos con prolongaciones nucleares, índice heterófilo linfocito.
Abstract: There are wild organisms that are highly vulnerable to anthropogenic and natural stressors, these organisms may be useful to assess environmental health through various reliable, simple, rapid, inexpensive indicators and to determine and if possible reduce these negative effects. In this study we propose that the snow goose (Chen caerulescens) to be tested as stress and environmental biomonitor of genotoxicity, by heterophil/lymphocyte (h/l) ratio, micronucleus test (MNE), nuclear protrusions in erythrocytes (NPE) and polichromatic erythrocytes (PCE). During the hunting season (2012-2013) in the wetland of Malaga, Durango, Mexico, 18 organisms were collected. Erythrocytes were the most abundant cells with elliptical morphology and nucleus, size of 12.68 ± 0.89, regular contour and nucleus-cytoplasm ratio 1:2. We observed heterophils (11.07 ± 1.32 µm), eosinophils (9.67 ± 1.26 μm), basophils (5.75 ± 0.78 µm), monocytes (10.49 ± 1.36 μm) and lymphocytes (6.53 ± 1.0 µm). No alteration in the proportions or morphology of leukocytes was identified, however, a greater number of organisms are required to establish normal blood para meters basis for this species. h/l ratio was 0.41±0.11 this value is similar to that reported for this and other bird species classified as healthy. MNE basal rate (2.6 ± 1.45), NPE (249.2 ± 89.74) and PCE (156.5 ± 50) was established. The snow goose is an organism that is emerging as a good candidate for environmental biomonitor due to basal frequency of h/l, MNE, NPE and PCE, but must be tested under standardized conditions and through studies in areas with and without pollution.
Keywords: Biomonitor, Chen caerulescens, micronucleated erythrocytes, erythrocytes with nuclear protrusions, heterophil/lymphocyte ratio.
Editor asociado: Diego Santiago Alarcón
Introducción
La contaminación del ambiente por causas antropogénicas es un problema mundial que va en incremento (Botello et al. 2015), sus consecuencias son múltiples y diversas, cada una de ellas digna de soluciones inmediatas. El daño por agentes físicos o químicos en el material genético como los cromosomas o el adn se estudia en términos de genotoxicidad (Newman 2010), el daño genotóxico habitualmente es silencioso, pasa inadvertido y se puede expresar como mutagénico, teratogénico o cancerígeno (Mathews 2015).
Los resultados suelen ser muy dramáticos ya que ponen en riesgo la vida del organismo e incluso sitúan en peligro de extinción a la especie. Por ello es importante contar con biomonitores e implementar sistemas de monitoreo que brinden información oportuna. Los métodos para evaluar el riesgo o protección a genotóxicos con frecuencia son costosos, complicados e invasivos. Ante este panorama la técnica de micronúcleos (MN) que permite la detección de genotóxicos, mutagénicos, teratogénicos e inestabilidad genómica, ofrece una gran oportunidad. Esta técnica es una prueba precisa, confiable, mínimamente invasiva, no se requiere de cultivos celulares, es rápida, sencilla y relativamente económica. Además, a estas cualidades se suman la versatilidad de aplicación en diversos organismos, tejidos y modelos, y no requiere de instalaciones especiales ni del sacrificio de los organismos (Zúñiga et al. 1996, Torres-Bugarín et al. 2014).
Biomonitores y biomarcadores
La cuantificación de contaminantes en suelo, agua o aire no permite evaluar la biotransformación, la biodisponibilidad o los efectos sobre los organismos, por eso se complementa con la biomonitorización que facilita la medición cualitativa o cuantitativa de exógenos o sus metabolitos en los organismos o en el ecosistema (Capó 2007). Biomonitores pueden considerarse los organismos vivos sensibles a cambios ambientales (Markert et al. 2003, Capó 2007, Needham et al. 2007) o bien especies acumuladoras de contaminantes a niveles que permiten ser evidenciados antes que en muestras abióticas (Spahn y Sherry 1999). Un buen monitor debe tener representatividad espacial y ecológica, disponibilidad y accesibilidad, sensibilidad, longevidad de la especie y reproducibilidad (Tataruch y Kierdorf 2003).
Específicamente, el grupo de aves es muy diverso, sus integrantes habitan en múltiples ambientes, sus respuestas a estresores naturales y antropogénicos son muy variadas (Mallory et al. 2010, Páez-Osuna y Osuna-Martínez 2011, Shepherd y Somers 2012). En particular, las aves acuáticas son candidatas a ser biomonitores por su amplia distribución, su abundancia y representatividad en el ecosistema (Markert et al. 2003, Mallory et al. 2010). Éstas se desenvuelven en diferentes partes de las redes tróficas y sus respuestas a los cambios ambientales pueden ir desde ligeros efectos fisiológicos hasta deformaciones o muerte (Hoffman et al.1996, Mallory et al. 2010). Adicionalmente existe la necesidad de realizar estudios que permitan la conservación, protección y uso adecuado de las aves acuáticas que migran cada año hacia centro y Sudamérica (Barba 2006). En este grupo encontramos al ganso nevado (Chen caerulescens), es una ave anseriforme de la familia Anatidae, la cual se reproduce en el Ártico, en áreas pantanosas de la tundra en Canadá, Alaska, Groenlandia, además de la isla Wrangell del extremo nororiental de Siberia, y migra al sur para sus estancias de residencia tropical en en Japón y a lo largo de la parte central y meridional de Norteamérica y centro-norte de México, su hábitat invernal son los pantanos, campos de cultivo, praderas, charcos y bahías (Heyland 2000, Peterson y Chalif 2008). Se alimenta de raíces, bulbos, brotes y hojas (BirdLife International 2015). Esta ave posee características ideales para ser considerada biomonitor, entre ellas su situación poblacional estable, su amplia distribución geográfica, su dieta, el tipo de hábitat en donde se alimenta y por que recorre grandes distancias (Bellrose 1976, Heyland 2000).
El riesgo de deterioro de la salud de cualquier organismo puede ser evaluado mediante marcadores biológicos conocidos como biomarcadores, éstos pueden ser alteraciones celulares, bioquímicas o moleculares, medibles en tejidos, células, o fluidos, o bien características biológicas que puedan ser cuantificadas en procesos fisiológicos, patológicos, respuestas farmacológicas, evaluación experimental, medición de riesgo ambiental y epidemiológico (Mayeux 2004). Dentro de los biomarcadores se identifican tres grupos: 1) de exposición, 2) de efecto y 3) de susceptibilidad (Arango 2012).
Eritrocitos micronucleados (EMN) como biomarcador de genotóxicos
En función de las características necesarias para la elección de un buen biomonitor mediante la técnica de micronúcleos (MN) en sangre periférica, se considera que las aves son un grupo adecuado debido a que tienen un bazo pequeño y pobre en elementos reticuloendoteliales, eritropoyesis muy activa, incluso más alta que los mamíferos, el recambio celular es aún mayor y la relación citoplasma-núcleo por lo general es 1:2 (Aschoff 1928, Ramírez-Muñoz et al. 1999, Udroiu 2006, Gómez-Meda et al. 2008, Clark et al. 2009,Weiss y Wardrop 2010, Shepherd y Somers 2012). Un MN (en hematología mejor conocido como cuerpo de Howell-Jolly) puede ser un fragmento o un cromosoma completo que durante la división celular se perdió debido a un daño en el uso mitótico (daño aneuploidogénico) o bien a la fractura de un cromosoma (daño clastogénico). En eritrocitos los MN se forman en médula ósea, luego se liberan en sangre periférica y si el sistema reticuloendotelial es eficiente éste será retirado en muy poco tiempo, de lo contrario permanecerá por un periodo prolongado en sangre periférica, y es cuando pueden ser visualizados más fácilmente (Ramírez-Muñoz et al. 1999). Un reticulocito es un eritrocito joven (eritrocito policromático - EPC) que aún contiene RNA y son indicadores de eritropoyesis o citotoxicidad, un EPC en 24 h se transforma en eritrocito normocromático, el cual, en las aves, permanece en circulación durante 25-28 días. Por tanto si se detecta frecuencia mayor de 3 eritrocitos micronucleados en 10 000 eritrocitos totales (EMN) se considera daño crónico y si son EPC micronucleados (EPCMN) muestra daño ocurrido en menos de 24 h (Schmid 1975, Zúñiga et al. 2001).
Conteo diferencial leucocitario
El principal componente del sistema inmunitario de los vertebrados está mediado por los leucocitos y en las aves existen cinco tipos: heterófilos, eosinófilos, basófilos, linfocitos y monocitos (Gershwin et al. 1985). El aumento o disminución de un determinado tipo de leucocito, además de reflejar enfermedades, también responden al grado de estrés a que está sometido un organismo, incluso estrés por malnutrición y pérdida de peso significativa o un ejercicio físico extremo (Gershwin et al. 1985, Maxwell y Robertson 1998). Los eventos estresantes incrementan los heterófilos y disminuyen los linfocitos, razón por la cual la proporción heterófilos/linfocitos (H/L) es aceptada como una medida de respuesta fisiológica de inmunosupresión y estrés (Davis et al. 2008, Cirule et al. 2012, Genovese et al. 2013).
El propósito de este estudio fue evaluar la relación h/l, frecuencia de EMN, EPN y EPC en sangre del ganso nevado (Chen caerulescens) para generar valores de referencia y evaluar su factibilidad como biomonitor ecotoxicológico.
Métodos
Descripción del área de estudio
El sitio de colecta se ubica al noroeste de la ciudad de Durango (24°07’00” N, 104°30´20” O y altitud de 1 861 m), forma parte de la Unidad de Manejo Ambiental (UMA) del Ejido “El Arenal” (registro SEMARNAT-UMA-EX0336-DGO), con superficie total de 5 246 ha, el uso de suelo es agropecuario. La colecta del ganso nevado (Chen caerulescens) la realizamos en coordinación con los grupos de cazadores que visitaron la UMA durante la temporada de caza de diciembre de 2012 a enero de 2013. Por tanto, la toma de muestras la realizamos en dos momentos diferentes, una en diciembre (6 organismos) y otra en enero (12 ejemplares), esto significa que las aves arribaron a México aproximadamente entre 40 y 80 días antes de tomar las muestras. En el sitio de colecta pesamos cada ave (báscula Torrey Modelo leq 10/20, con precisión de 0.02 kg), definimos la edad como joven o adulto según la coloración del plumaje y presencia de muda o estado de las plumas primarias. C. caerulescens es una especie cuyas hembras y machos tienen una fisonomía similar por lo que los sexamos mediante necropsia. A cada individuo le tomamos una muestra de 0.5 mL de sangre y realizamos dos frotis de cada ejemplar sobre un portaobjetos previamente limpio, desengrasado y codificado, dejamos secar al aire libre y fijamos en etanol al 80% durante 10 minutos y posteriormente realizamos la tinción.
Los frotis sanguíneos los teñimos con solución Wright-Giemsa durante 5 minutos, luego agregamos 10 gotas de tiosulfato de sodio y dejamos reposar durante 5 minutos, después lavamos las muestras con agua destilada y los secamos al aire libre. Para el conteo diferencial leucocitario y posteriormente obtener el índice H/L contabilizamos 200 leucocitos por organismo con el microscopio 100x (zeiss modelo Axiostar plus) (Maxwell y Robertson 1998, Ontiveros-García 2006).
El análisis de eritrocitos micronucleados (EMN) y prolongaciones nucleares en eritrocitos (EPN) lo realizamos con dos tinciones Wright-Giemsa y anaranjado de acridina (tinción altamente específica para ácidos nucleicos, que tiñe DNA verde limón y el RNA anaranjado), para el análisis con la primer tinción utilizamos el mismo frotis para el diferencial leucocitario, y para el análisis con anaranjado de acridina utilizamos el segundo frotis de cada individuo. Los frotis fijados y teñidos con anaranjado de acridina los analizamos con un microscopio equipado con fluorescencia (100x) (zeiss modelo Axiostar plus). Por cada tinción cuantificamos 10 000 eritrocitos totales en los que identificamos la frecuencia de EMN y EPN, y contabilizamos la frecuencia de EPC en 1000 eritrocitos totales (Gómez et al. 2006).
Análisis estadístico
Realizamos el análisis de normalidad de los datos (Shapiro-Wilk) e igualdad de varianzas (Levene), y calculamos los estadísticos más relevantes (promedio, desviación estándar, rangos) para las variables de estudio como peso de las aves (kg), diámetro mayor y menor (µm) de las células sanguíneas, frecuencia de leucocitos y en eritrocitos la frecuencia de EMN, EPN y EPC. Utilizamos la prueba de Tukey (α=0.01) para realizar las comparaciones entre las medias de los estadísticos evaluados para cada sexo. Para todos los análisis usamos el programa estadístico ncss (Hintze 2001).
Resultados
Durante la temporada de caza 2012-2013 en el humedal de Málaga, Durango, México, colectamos 18 organismos adultos, de los cuales cinco fueron hembras, seis machos y siete sin sexar porque implicaba hacer necropsia y los cazadores deseaban conservar las aves. El peso promedio fue de 1.867 ± 0.261 kg, con rango de 1.478 a 2.354 kg, sin diferencias estadísticas (p= 0.287) entre sexos.
Diferencial leucocitario y relación H/L
El análisis del frotis sanguíneo de Chen caerulescens nos permitió establecer que los eritrocitos normales fueron las células más abundantes, su diámetro mayor fue de 12.68 ± 0.89 µm (n= 700, mínimo 11 µm y máximo 15 µm), el diámetro menor fue de 6.41 ± 0.3 µm (n= 700, mínimo de 5 µm y máximo 9 µm), el núcleo de estas células es elíptico de contornos regulares, con diámetro mayor de 6.44 ± 0.14 µm, por tanto la relación citoplasma-núcleo es de 1:2. Dentro de los leucocitos observamos cinco tipos celulares: heterófilos, los más abundantes (11.07 ± 1.32, 8-13.5 µm), linfocitos (6.53 ± 1.0 µm; 4.9-9 µm), eosinófilos (9.67 ± 1.26 µm; 6.9-12.3 μm), monocitos (10.49 ± 1.36; 7.5- 13.2 µm), basófilos (5.75 ± 0.78; 4.1 - 7.3 μm) (Cuadro 1). La proporción h/l fue de 0.41 ± 0.11, no hubo diferencias significativas (p>0.01) entre frecuencia de leucocitos y relación h/l (p=0.4825) para organismos de diferente sexo.

Cuadro 1
Diferencial leucocitario, frecuencia de micronúcleos y prolongaciones nucleares en eritrocitos en el ganso nevado (Chen caerulescens).
g gramos; Diferencial leucocitario en 200 leucocitos (Mon-Monocitos; Eos-Eosinófilos; Bas-Basófilos; Het-Heterófilos; Lin-Linfocitos). En 1000 eritrocitos totales (ET) (EPC- Eritrocitos policromáticos). En 10 000 et- (EMN- Eritrocitos micronucleados; EPN- eritrocitos con prolongaciones nucleares).
Frecuencia de EPC, EMN y EPN
La frecuencia basal de EMN fue de 2.63 ±1.45 con rango de 0-5. La frecuencia basal de EPN fue de 249.25 ± 89.74 con rango de 95 - 458 y en cuanto a la de EPC fue de 156.56 ± 50.01 con rango de 71- 227 (Figuras 1, 2 y 3).
Figura 1
Sangre de Chen caerulescens, Eritrocito policromático (EPC), Eritrocito con prolongación nuclear (EPN), Tinción: anaranjado de acridina (100x).
Figura 2
Sangre de Chen caerulescens, Eritrocito micronucleado (EMN), Tinción: anaranjado de acridina (100x).
Figura
3. Sangre de Chen caerulescens, Eritrocito policromático (EPC), Tinción Wrigth-Giemsa (100x).
Discusión
Algunos valores hemáticos de los gansos se modifican como resultado de cambios en su estado fisiológico asociados a su comportamiento migratorio (Williams y Trainer 1971), esto podría observarse en fechas cercanas (octubre y noviembre) a su llegada a los sitios de residencia no reproductiva en México. La toma de muestras la realizamos aproximadamente entre 40 y 80 días después del arribo de las aves, y debido a que las células hemáticas viven en promedio 28 días, podemos entender que nuestros resultados reflejan los factores ambientales prevalecientes en el sito de colecta. Sin embargo, sería interesante determinar la frecuencia leucocitaria, el índice h/l, así como la frecuencia de EMN, EPN y EPC al momento del arribo y por supuesto antes de la migración en su lugares de origen, incluso evaluar el comportamiento de estos parámetros de acuerdo con su edad aproximada, peso y sexo.
Diferencial leucocitario y relación h/l
El conteo para el diferencial leucocitario se recomienda entre 100 y 200 células, en este caso cuantificamos 200 leucocitos por organismo, y está descrito que los conteos leucocitarios se modifican en condiciones de estrés, enfermedades y otros factores (Davis et al. 2008, Cirule et al. 2012, Genovese et al. 2013). En Chen caerulescens no identificamos alteraciones en las proporciones ni en la morfología de leucocitos descrita para otras especies de gansos y no encontramos hemoparásitos. Sin embargo, reconocemos que para establecer los parámetros sanguíneos de base normal para una especie, es necesario una muestra de mayor tamaño que represente una amplia gama demográfica de los animales, por ello se necesitan más evaluaciones para esta especie (Charles-Smith et al. 2014). Por otro lado, si bien el índice h/l no debe de ser el único parámetro para valorar la salud y condición inmunológica de las aves, reconocemos que es un buen indicador de estresores agudos y crónicos (Álvarez 2010, Cotter 2015). Las aves en respuesta a factores de estrés aumentan la actividad del eje adrenal hipotálamo-hipófisis, dando lugar a concentraciones elevadas de glucocorticoides, lo que induce a su vez aumento de la frecuencia de heterófilos (células equivalentes a los neutrófilos de los humanos), y disminución en los linfocitos, a esta circunstancia se define como elevado índice h/l (Meer y Oers 2015). Los heterófilos son la primera resistencia natural contra infecciones bacterianas y otros agentes (Gross y Siegel 1983, Cirule et al. 2012) entonces este parámetro se correlaciona con inmunosupresión, con bajas tasas de crecimiento, supervivencia, niveles elevados de glucocorticoides y estrés.
El índice H/L en C. caerulescens fue de 0.41 ± 0.11, dato similar al descrito por Williams y Trainer (1971) h/l 0.31 y al de otras especies calificadas como sanas (Cuadro 2). El playero ártico (Calidris canutus rufa) es un ave migratoria que habita el norte del continente americano cuyo índice h/l es similar en su época reproductiva (0.4 ± 0.1), sin embargo este índice se modifica durante su estancia invernal (1.4 ± 0.1) (D’amico 2011).

Cuadro 2
Relación heterófilo/linfocito (H/L) en diferentes especies de aves.
Frecuencia de EMN
La formación de MN es un marcador ampliamente explotado para evaluar agentes genotóxicos, pues estas estructuras pueden ser identificadas sencillamente en cualquier célula somática o germinal que se divida. Específicamente en sangre es factible su uso por la facilidad para obtener la muestra, a la abundancia de células y no se arriesga la vida del organismo. En mamíferos los eritrocitos son anucleados, lo que permite la detección de los mn, no obstante en ellos es fundamental considerar la funcionalidad del bazo para que un organismo pueda ser utilizado como biomonitor de genotóxicos, pues en muchos mamíferos este órgano es el principal responsable de eliminar glóbulos rojos viejos, anómalos o que se encuentran en mal estado, esto dependiendo de si el bazo es sinusoidal (altamente vascularizado) o no sinusoidal (Udroiu 2006). En cambio, en organismos no mamíferos el bazo no compromete la prueba de MN ya que este órgano no es sinusoidal y posee vénulas fenestradas que permiten que sus eritrocitos nucleados pasen fácilmente (Udroiu 2006). Particularmente en las aves, el bazo es un órgano secundario linfoide muy pequeño, de forma redondeada, se localiza al costado derecho, entre el proventrículo y el estómago muscular; sus funciones principales son captar los antígenos circulantes en la sangre, activar los macrófagos y desencadenar la producción de células plasmáticas específicas, y probablemente la función de eliminación de eritrocitos anómalos o con inclusiones, como los MN, quede relegado al resto del sistema reticuloendotelial como serían macrófagos libres, ganglios o hígado (Hernández 1998).
En este caso el ganso nevado presentó 2.63 ±1.45; rango de 0-5 EMN/10 000 (Cuadro 1), entonces sugiere que es un organismo con bazo no sinusoidal y que el resto del sistema retículo endotelial no es lo suficientemente eficiente como para remover de la circulación todos los eritrocitos viejos, anómalos o con inclusiones, por lo tanto podría ser un orga nismo ideal para ser utilizado con fines de monitoreo ambiental nacional y trasnacional. En un estudio en el que incluyeron mamíferos, reptiles y aves, describen ausencia de EMN en C. caerulescens (Cuadro 3), no obstante en esa ocasión sólo se utilizaron muestras de aves en cautiverio y dos organismos en vida silvestre (Zúñiga et al. 2001). En ese mismo estudio se proponen como monitores aquellos organismos que presentaron más de 3.5 EMN/10 000 eritrocitos totales y consideran que la edad del organismo es importante, ya que al menos en la ardilla gris la frecuencia de EMN espontáneos es más abundante, dato que posteriormente corroboran mediante un estudio experimental (Zúñiga et al. 2001). Por otro lado, en el perico atolero (Aratinga canicularis) la frecuencia de EMN fue 3/10 000, dato muy similar al del ganso nevado, y al ser expuesto a genotóxicos la frecuencia se incrementó hasta 6/10,000 EMN (Gómez et al. 2006). Es recomendable realizar la exploración de MN en las diferentes familias de aves y detectar aquellas que posean un sistema retículo endotelial deficiente para poder identificar fácilmente los EMN espontáneos o inducidos y poder proponer biomonitores de agentes genotóxicos ambientales.

Cuadro 3
Eritrocitos micronucleados (EMN)/10 000 ET en diferentes especies de aves.
Frecuencia de EPN
Los eritrocitos de las aves son típicamente elípticos con núcleo central, pero con frecuencia la morfología nuclear muestra variantes, como núcleos simétrica y asimétricamente constreñidos, bilobulados, binucleados y microlobulados (Clark et al. 2009). Al igual que los mn, estas alteraciones son consideradas como potenciales marcadores de genotoxicidad (Serrano-García y Montero-Montoya 2001, Gómez et al. 2006); por ejemplo, en el perico atolero (A. canicularis), se le administró una inyección intracoelomica de 4 mg/kg mitomicina-C, y observamos incremento paralelo tanto en los EMN (0 horas 2.89± 2.4/72 horas 6.09 ± 2.5) como en los EPN (0 horas 8.89 ± 6.8/72 horas 14.29±4.4), por lo tanto ambos parámetros deben ser considerados en estudios de toxicología genética ambiental (Gómez et al. 2006).
En el ganso nevado el promedio de EPN fue de 249.25 ± 89.74 /10 000 et, pero no existe información previa que permita comparar nuestros resultados. Sin embargo, el promedio de EPN obtenido es superior al compararlo con los valores encontrados en otras especies de aves (Cuadro 4), lo que sugiere que este biomarcador podría ser muy sensible en estudios toxicológicos. En nuestros resultados el número de EMN fue menor al número de EPN, lo cual es consistente con los experimentos realizados con la especie A. canicularis, y que la frecuencia de estas dos anormalidades se incrementa de forma paralela (Gómez et al. 2006). En el estudio con el págalo antártico (Catharacta maccormicki) la cantidad de EPN fue diez veces superior a la de EMN (Krusa y Bezrukov 2007). Este comportamiento sugiere que la formación de EPN puede deberse a un espectro de factores más amplio que las que originan la formación de los EMN (Gómez et al. 2006). Una consideración importante que se observa en los estudios citados (Cuadro 4) es que los valores de EPN tuvieron una gran variabilidad ocasionada posiblemente por tratarse de aves de diferente sexo, edad y peso, lo cual se relaciona con la madurez del sistema retículo endotelial de las aves y a su capacidad para remover células dañadas de la circulación.

Cuadro 4
Prolongaciones nucleares (EPN) descritos en diferentes especies de aves.
Eritrocitos policromáticos con micronúcleos y prolongaciones nucleares
En aves el periodo de vida de un eritrocito es de 25 a 28 días (Dukes y Swenson 1981), promedio menor al de los mamíferos que es de 120 días aproximadamente, esto confiere la posibilidad de realizar estudios a corto plazo. No obstante es necesario identificar los posibles efectos genotóxicos en plazos mucho más cortos, y es cuando son útiles los valores de EPC con micronúcleos (EPCMN). Pero no todas las especies animales tienen EPC, afortunadamente el ganso nevado tiene muy buenas frecuencias de EPC 156.56 ± 50.01/1000 eritrocitos totales. No se observaron EPCMN y EPCPN en los 16 organismos analizados. La presencia de estas anormalidades se sugiere que sucede durante la exposición crónica (niveles elevados de xenobióticos y periodos de tiempo prolongados) a ciertas sustancias contaminantes (Navarro y Benítez 1995).
El ganso nevado (Chen caerulescens) es un organismo que puede ser considerado como buen candidato a biomonitor ambiental debido a la frecuencia basal de su relación h/l, EMN, EPN y EPC, pero debe probarse en condiciones estandarizadas y a través de estudios en zonas con y sin contaminación. De manera complementaria se requiere hacer estas mismas determinaciones en especies de aves antes de la migración, así como a individuos de diferentes edades.
Agradecimientos
Al MVZ Jorge Bretón por las facilidades y acompañamiento durante la colecta, al M.C. Daniel Sierra Franco y MVZ Alicia Zulema Cárdenas González por su apoyo en la colecta de aves. A los revisores y editores por sus valiosos comentarios y aportaciones a este manuscrito.
Literatura citada
Arango, S.S. 2012. Biomarcadores para la evaluación de riesgo en la salud humana. Revista Facultad Nacional Salud Pública 30(1):75-82.
Aschoff, L. 1928. Sistema retículo-endotelial y formación de los pigmentos biliares. Anales de la Real Academia de Medicina y Cirugía de Barcelona 10:81-82.
Álvarez M.I. 2010. Perfil hematológico y hemoparásitos de una población residente del verdugo americano (Lanius ludovicianus, Lannidae: AVES) en Michoacán, México. Tesis de licenciatura en Biología. Facultad de Biología. Universidad Michoacana de San Nicolás de Hidalgo, México.
Barba C.G. 2006. Identificación de patrones conductuales del ganso nevado (Chen caerulescens) en la subcuenca Sayula y su relación con la calidad del hábitat. Tesis doctoral. Universidad de Guadalajara Centro Universitario de Ciencias Biológicas y Agropecuarias. Zapopan, Jalisco, México.
Branton, S.L., J.D. May, B.D. Lott y W.R. Maslin. 1997. Various blood parameters in commercial hens acutely and chronically infected with Mycoplasma gallisepticum and Mycoplasma synoviae. Avian Diseases 41: 540-547.
Bellrose, F.C. 1976. Ducks, Geese, & Swans of North America, A Wildlife Management Institute Book: Stackpole Books: Harrisburg, Pennsylvania, 17105.
BirdLife International (en línea). 2015 Species factsheet: Anser caerulescens. Disponible en: <Disponible en: http://www.birdlife.org > (consultado el 5 de diciembre de 2015).
Botello, A.V., F. Páez-Osuna, L. Méndez-Rodríguez, M. Betancourt-Lozano, S. Álvarez-Borrego, R. Lara-Lara. 2015. Pacífico Mexicano, Contaminación e impactos ambientales: Diagnóstico y tendencias. UAC, UNAM-ICMYL, CIAD-Mazatlán, CIBNOR, CICESE.
Capó, M.M. 2007. Principios de Ecotoxicología. Diagnóstico, tratamiento y gestión del medio ambiente. Ed. Tébar, S.L., Madrid, España.
Charles-Smith, L.E., M.E. Rutledge, C.J. Meek, K. Baine, E. Massey, L.N. Ellsaesser, Ch.S. DePerno, Ch.E. Moorman, y L.A. Degernes. 2014. Hematologic parameters and hemoparasites of nonmigratory Canada Geese (Branta canadensis) from Greensboro, North Carolina, USA. Journal of Avian Medicine and Surgery 28(1):16-23 doi: 10.1647/2012-072.
Cirule, D., T. Krama, J. Vrublevska, M.J. Rantala e I. Krams. 2012. A rapid effect of handling on counts of white blood cells in a wintering passerine bird: a more practical measure of stress? Journal of Ornithology 153:161-166.
Clark, P., W. Boardman y S. Raidal. 2009. Atlas of Clinical Avian Hematology. Blackwell Publishing, USA.
Cotter, P.F. 2015. An examination of the utility of heterophil-lymphocyte ratios in assessing stress of caged hens. Poultry Science 94:512-517.
D’amico, V.L. 2011. Conteos leucocitarios en el playero rojizo (Calidris canutus rufa) en Patagonia, Argentina. Hornero 26(2):73-77.
Davis, A.K., D.L. Maney y J.C. Maerz. 2008. The use of leukocyte profiles to measure stress in vertebrates: a review for ecologists. Functional Ecology 22:760-777.
Dukes, H.H. y M.J. Swenson. 1981. Fisiología de los animales domésticos. Tomo I. Funciones vegetativas. Colección ciencia y técnica. Editorial Aguilar, México.
Fox, G.A., K.A. Grasman y G.D. Campbell. 2007. Health of herring gulls (Larus argentatus) in relation to breeding location in the early 1990s. II. Cellular and histopathological measures. Journal of Toxicology and Environmental Health, Part A, 70:1471-1491.
Gershwin, M., R.S. Beach y L.S. Hurley. 1985. Nutrition and immunity. Academic Press, London.
Genovese, K., H.H. Swaggerty y M.H. Kogut. 2013. The avian heterophil. Developmental & Comparative Immunology 41(3):334-340. doi: 10.1016/j.dci.2013.03.021.
Gómez M., B.C., A.L. Zamora-Pérez, J. Luna-Aguirre, A. González-Rodríguez, M.L. Ramos-Ibarra, O. Torres-Bugarín, C.M. Batista-González y G.M. Zúñiga-González. 2006. Nuclear abnormalities in erythrocytes of parrots (Aratinga canicularis) related to genotoxic damage. Avian Pathology 35(3): 206-210.
Gómez M., B.C., A.L. Zamora Pérez y G.M. Zuñiga González. 2008. Genotoxicity and biomonitoring; Micronuclei in peripheral blood and epithelial cells. Pp 145-182. In: H. Kimura, A. Suzuki (eds.). New Research on DNA Damage. Nova Science Publishers, USA.
Gross, W.B. y H.S. Siegel. 1983. Evaluation of the heterophil/lymphocyte ratio as a measure of stress in chickens. Avian Diseases 27(4):972-979.
Hauptmanova, K., I. Literak y E. Bartova. 2002. Hematology and leukocytozoonosis of Great Tits (Parus major L.) during winter. Acta Veterinaria Brunensis 71:199-204.
Hernández B., M.A., 1998. Caracterización del desarrollo de la bolsa de Fabricio, timo y bazo en aves tipo Leghorn, libres de patógenos específicos (LPE). Tesis de licenciatura en Medicina Veterinaria. Valdivia, Chile.
Heyland, J. (en línea). 2000. Canadian Wildlife Service, Greater Snow Goose. Disponible en: < http://cwsscf.ec.gc.ca/hwwfap/greatsg/gsgoose.html > (consultado 2 de noviembre de 2013).
Hintze, J. 2001. NCSS and PASS. Number Cruncher Statistical Systems. Kaysville, Utah.
Hoffman, L., H. Hafner y T. Salathe. 1996. The contribution of colonial waterbirds research to wetland conservation in the Mediterranean region. Colonial Waterbirds 19(1):12-30.
Krusa, M. y V. Bezrukov. 2007. Health status in an Antarctic top predator: micronuclei frequency and white blood cell differentials in the South Polar Skua (Catharacta maccormicki). Polarforschung 77(1):15.
Mallory, M.L., S.A. Robinson, C.E. Hebert y M.R. Forbes. 2010. Seabirds as indicators of aquatic ecosystem conditions: A case for gathering multiple proxies of seabird health. Marine Pollution Bulletin 60:7-12.
Markert, B.A., A.M. Breure y H.G. Zechmeister. 2003. Bioindicators and biomonitors, principles, concepts and Applications. Trace metals and other contaminants in the environment, Vol. 6. Elsevier, USA.
Mathews, C.K. 2015. Deoxyribonucleotide metabolism, mutagenesis and cancer. Nature Reviews Cancer (9):528-539.
Matta-Camacho, N.E., J. Beltrán-Castañeda, Y.P. Gonzalez-Hernández, I. Lotta-Arévalo y N. Salcedo-Porras. 2014. ¿Varía el recuento diferencial de leucocitos en colibríes (Trochilidae) infectados por hemoparásitos? (resumen). Memorias de la Conferencia Interna en Medicina y Aprovechamiento de Fauna Silvestre, Exótica y no Convencional. Asociación de Veterinarios de Vida Silvestre. Colombia 10(2):195-196.
Maxwell, M.H. y G.W. Robertson. 1998. The avian heterophil leukocyte: a review. World’s Poultry Science Journal 54:155-178.
Mayeux, R. 2004. Biomarkers: potential uses and limitations. NeuroRx 1(2):182-188.
Meer E., V.D. y K. van Oers 2015. Gender and personality differences in response to social stressors in Great Tits (Parus major). Plos One 10(5): e0127984. doi:10.1371/journal.pone.0127984.
Navarro, A. y H. Benítez. 1995. El dominio del aire. Fondo de Cultura Económica, México. D.F.
Needham, L.L., A.M. Calafat y D.B. Barr. 2007. Uses and issues of biomonitoring. International Journal of Hygiene and Environmental Health 210 (3-4):229-238.
Newman M.C. 2010. Fundamentals of Ecotoxicology 3a. ed. CRC Press, Boca Raton, FL. USA.
Ontiveros-García, L.A. 2006. Efecto de las infestaciones causadas por el protozoario Amyloodinium coellatum (Brown, 1931) sobre los parámetros sanguíneos y filamentos branquiales del pargo lutjanero (Lutjanus guttatus) (Steindachneri 1869). Tesis de maestría. Centro de Investigación en Alimentación y Desarrollo-Mazatlán (CIAD-Mazatlán). Mazatlán, Sinaloa, México.
Páez-Osuna, F., C. Osuna-Martínez. 2011. Biomonitores de la contaminación costera con referencia a las costas mexicanas: una revisión sobre los organismos utilizados. Hidrobiológica 21 (3):229-238.
Pérez G., R.A., E. Montes de Oca Herrera, E. Zenteno Galindo y C. Sierra Castillo. 2008. Análisis de los grupos celulares sanguíneos en diferentes especies de aves por el método de Romanowsky. Memoria de Resúmenes del IX Congreso Nacional de Microscopía, León, Guanajuato, México.
Peterson, R.T. y E.L. Chalif. 2008. Aves de México Guía de campo. Diana, México.
Ramírez-Muñoz, M.P., G. Zúñiga, O. Torres-Bugarín, E. Portilla, D. García-Martínez, A. Ramos, J.M. Cantú y J. Sánchez-Corona. 1999. Evaluation of the micronucleus test in peripheral blood erythrocytes by use of the splenectomized model. Laboratory Animal Science. 49(4):418-420.
Ross-Muñoz, S. 2011. Utilización de biomarcadores para evaluar los efectos de Hg y Pb en aves migratorias del noroeste de México. Tesis de maestría. Centro de Investigación en Alimentación y Desarrollo-Mazatlán (CIAD-Mazatlán). Mazatlán, Sinaloa, México.
Schmid, W. 1975. The micronucleus test. Mutation Research 31(1):9-15.
Serrano-García, L. y R. Montero-Montoya. 2001. Micronuclei and chromatid buds are the result of related genotoxic events. Environmental Molecular Mutagenesis 38:38-45.
Shepherd, G.L. y C.M. Somers. 2012. Adapting the buccal micronucleus cytome assay for use in wild birds: age and sex affect background frequency in pigeons. Environmental and Molecular Mutagenesis 53 (2):136-144.
Spahn, S.A. y T.W. Sherry. 1999. Cadmium and lead exposure associated with reduced growth rates, poorer fledging success of little blue heron chicks (Egretta caerulea) in south Louisiana wetlands. Archives of Environmental Contamination and Toxicology 37:377-384.
Tataruch, F. y H. Kierdorf. 2003. Mammals as bioindicators. Pp 737-772. In: B.A. Markert, A.M. Breure y H.G. Zechmeister (eds.). Bioindicators and Biomonitors: Principles, Concepts and Applications. Elsevier Science, Amsterdan, Holland.
Torres-Bugarín, O., M.G. Zavala-Cerna, A. Nava, A. Flores-García, M.L. Ramos-Ibarra. 2014. Potential uses, limitations, and basic procedures of micronuclei and nuclear abnormalities in buccal cells. Disease Markers. 2014:1-14. doi:10.1155/2014/956835.
Udroiu, I. 2006. The micronucleus test in piscine erythrocytes. Aquatic Toxicology 79:201-204.
Weiss, D.J. y K.J. Wardrop. 2010. Veterinary Hematology, 6th Edition. Wiley-Blackwell, USA.
Williams, J.I. y D.O. Trainer. 1971. A hematological study of snow blue and Canada geese. Journal of Wildlife Diseases 7:258-264.
Zúñiga G., G.M., O. Torres-Bugarín, M.P. Ramírez-Muñoz, A. Ramos, E. Fanti-Rodríguez, E. Portilla, D. García-Martínez, J.M. Cantú, M.P. Gallegos-Arreola, J. Sánchez Corona. 1996. Spontaneous micronuclei in peripheral blood erythrocytes from 35 mammalian species. Mutation Research 369:123-127.
Zúñiga G., G.M., O. Torres-Bugarín, A. Zamora-Pérez, B.C. Gómez-Meda, M.L. Ramos Ibarra, S. Martínez-González, A. González-Rodríguez, J. Luna-Aguirre, A. Ramos-Mora, D. Ontiveros-Lira, M.P. Gallegos-Arreola. 2001. Differences in the number of micronucleated erythrocytes among young and adult animals including humans Spontaneous micronuclei in 43 species. Mutation Research 494:161-167.
Notas de autor
* Correo electrónico: mepereda@ujed.mx